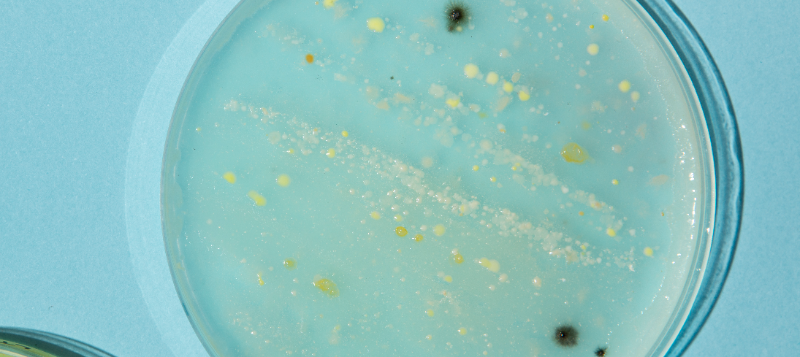
petridish22-800x357
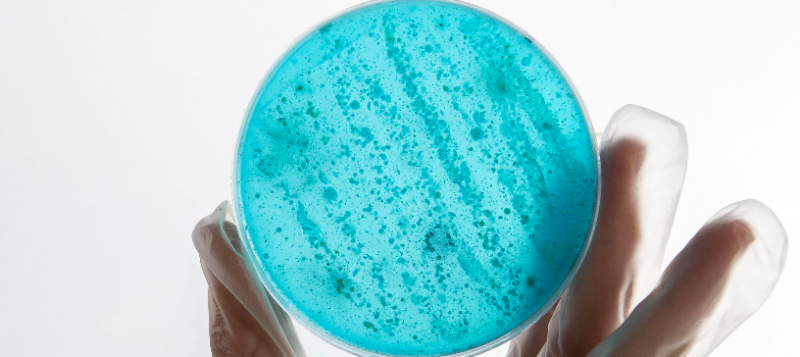
petridish800x357
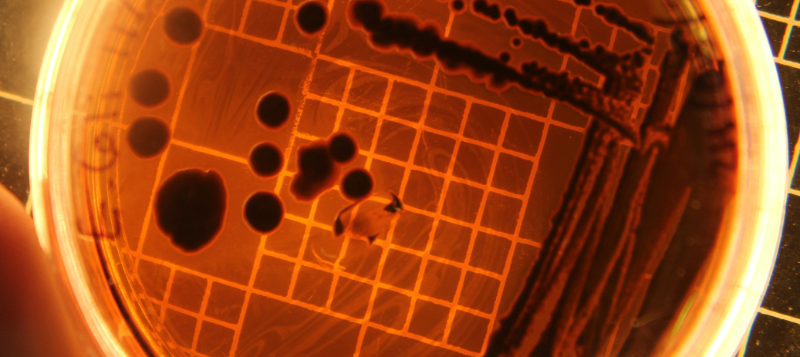
darkpd800x357

Frequently Asked Questions


What is the Soil Life Monitor used for?
Soil Life Monitor is used by farmers, advisers and research institutes. It provides information on the microbial life in the soil by mapping the microorganisms.
Results
The test results of Soil Life Monitor can be used for benchmarking and comparison between different management styles.
Compost
Soil Life Monitor can help you to answer many questions, such as whether the addition of compost can have a positive effect.
Organic matter
Microbial life flourishes at high amounts of organic matter. Organic matter stores carbon, coming from CO2 in the atmosphere, and increases the water-holding capacity of the soil.
Healthy soil
Healthy soil is resilient soil and can better cope with various stresses, such as drought, floods, extreme temperatures, pests, diseases, and land-use changes.
Balanced soil life
Balanced soil life is the basis of resilient soil, and of sustainable agriculture and natural systems.
Microbial biomass
Compost can positively affect the microbial biomass and what the effect of no-tillage has on the fungal community in your soil.
Pathogens
A rich microbial ecosystem has less room for pathogens to grow because of competition.
Microorganisms
Bacteria and fungi break down organic matter, and in the process, nutrients are mineralized. These nutrients can be taken up by the plants. High microbial activity is therefore beneficial to plant.

What are protozoa?

What protozoa are
Protozoa are single-celled microorganisms with a nucleus (eukaryotes).
Their role in the soil
They make nutrients available to crops by ‘grazing’ on microorganisms, especially bacteria.
Dependence on moisture
Protozoan activity strongly depends on soil moisture and occurs mainly in water films and water-filled pores.
Protection of bacteria
Small pores can protect bacteria from protozoan grazing, limiting their access and activity.

What are actinomycetes?

What actinomycetes are
Actinomycetes are special bacteria that form thread-like filaments similar to fungal hyphae, but they have no nucleus and their cell walls lack cellulose or chitin.
Role in soil health
Some species, such as Streptomyces sp., produce antibiotics that naturally suppress pathogenic soil fungi and improve disease resistance.
Interactions with fungi
Certain actinomycetes act as parasites on fungal hyphae or spores, or compete with harmful fungi for nutrients in the soil.
Decomposition and humus formation
They break down complex organic materials like cellulose, lignin and chitin, supporting stable humus formation, better soil structure, CEC and water balance.
pH preference
Actinomycetes prefer neutral to slightly alkaline soils, thriving best at a pH between 6.5 and 8.0, and are less active in acidic conditions.

What are arbuscular mycorrhiza

Fungi
Arbuscular mycorrhiza are fungi that can enter into symbiosis with about 80% of all plant species. This fungi grows in and around the roots and supply the crop with nutrients in exchange for sugars.
Network
The larger the mycelium (network of fungal threads or hyphae) around the roots of a crop, the more nutrients, such as nitrate and phosphate, the plant can absorb.
Simbiosis
Crops that do not engage in symbiosis with arbuscular mycorrhiza are crops from the Cruciferae (cruciferous plants, e.g, cole crops) and Chenopodiaceae (goosefoot plants, e.g, spinach, beet) families.

What is the sampling protocol for Soil Life Monitor?

The best way to take a Soil Life Monitor sample depends on the substrate type and whether it’s outdoor or greenhouse soil.
Outdoor soil sampling
Plot sampling is done in the same way as for the fertiliser analysis. Take at least 40 cores in a W-shaped pattern over all or part of the plot. We recommend sampling a maximum area of 2 hectares.
Sampling depth and conditions
For most arable crops, samples should be taken up to 25 cm deep, and for grassland up to 10 cm deep. If possible, take samples in moist conditions and avoid sampling when the soil is very dry.
Collecting outdoor samples
Collect at least 1 liter of soil in a plastic or plastic-lined bag. Alternatively, you can have the samples taken by a Eurofins Agro sampler, who will record the exact GPS location.
Greenhouse soil sampling
Take 40 cores up to 25 cm deep across at least 8 bays, beds or rows of plants (max. 1 hectare). Collect 1 litre of soil in a plastic or plastic-lined bag for analysis.

How rapidly do phospholipid fatty acids (PLFAs) degrade once an organism dies?

PLFAs are known to degrade rapidly and are therefore indicative of living microorganisms. However, the rate at which the fatty acids degrade depends on environmental factors, particularly temperature.
Degradation rate and temperature
A recent study has shown that the half-life (t½) of various PLFAs is between 14 and 27 hours. Degradation at 15°C takes twice as long as at 20-25°C.
The half-life (t½)
The time after which exactly half of the original quantity of material remains
Effect of microbial biomass
The degradation rate was roughly the same in soils with a low and high microbial biomass.
Source
Zhang et al. (2019) – High turnover rate of free phospholipids in soil confirms the classic hypothesis of PLFA methodology.

How long does a Soil Life Monitor analysis take?

The maximum duration of an SoilMonitor analysis is three weeks after arrival of the sample at the Eurofins Agro lab in Wageningen.
What is the total number of fungi and bacteria in the soil

Total number
Microbial biomass is a quantified total of a large number of fatty acids. Fungi and bacteria make up the largest proportion of this but do not contain the entire microbial biomass.
Parameters measured
The unit of the parameters measured is mg PLFA/kg soil. The biomass of fungi, bacteria and microbial biomass in mg C/kg soil is calculated using a conversion factor known from literature.
What is the Shannon-Wiener index?

The Shannon-Wiener index (SWI)
Is a measurement of the ecological diversity of the groups of organisms that occur in the soil. The index uses the number of species and their abundance as input.
The value
The lowest value of the SWI is 0 (only 1 species present), and the maximum is dependent on the number of species when they are all present in the same abundance.
Six groups
The index is based on the six groups that are measured with Soil Life Monitor analysis: gram +, gram -, actinomycetes, saprophytes, mycorrhizae and protozoa.
What does the fungal-to-bacterial ratio indicate, and how is it calculated?

The fungal-to-bacterial ratio
The fungal-to-bacterial ratio indicates the ratio between the total fungal biomass and the total bacterial biomass (expressed in g C/kg soil).
Indicator
The ratio can also be used as an indicator for the extent of disturbance. In general, undisturbed ecosystems have a higher fungal-to-bacterial ratio than disturbed systems.
Biological and low-input systems
Biological and low-input systems have a higher fungal-to-bacterial ratio than conventional, enriched systems.
Disturbance
Forms of disturbance such as tillage, removal of crop residues and grazing cause this ratio to drop.

What does the Gram+/Gram- ratio indicate?

Bacteria
Bacteria can be divided into two different groups: Gram-negative (Gram-) and Gram-positive (Gram+).
Gram-positive bacteria
Gram-positive bacteria are generally larger than Gram-negative bacteria and can form spores. This makes them more resistant to drought and water stress.
Gram-negative
Gram-negative bacteria (<1) can tolerate different types of disturbance (forms of stress, such as ploughing and the use of pesticidesbetter) because they have an outer membrane.
Dominance
Gram-positive dominant populations (>1) are more common at the beginning of the growing season and balance out again when the soil conditions become more favorable.

What types of mycorrhizae are measured with the Soil Life Monitor?

The PLFA analysis provides insights into the biomass of the active mycelium (network of fungal threads or hyphae) of arbuscular mycorrhizae in the soil. The fatty acid 16:1ω5 is used for this purpose.

What is the 'PLFA method'?

What is the 'PLFA method'?
The biological parameters of Soil Life Monitor are analysed using the PLFA method. PLFA stands for phospholipid fatty acids. These fatty acids occur in the cell membranes of living organisms.
Unique compositions
Different groups of organisms have unique compositions of PLFAs. By measuring and quantifying PLFAs, it is possible to obtain a fingerprint of the soil food web.
Cell membranes
Cell membranes of fungi consist of different PLFAs than those found in bacteria. The PLFAs present are measured and quantified using gas chromatography-mass spectrometry (GC-MS).

Can the PLFA method also identify soil life at species level?

Can the PLFA method also identify soil life at species level?
No, the PLFA method can only distinguish between groups of microorganisms such as actinomycetes and arbuscular mycorrhizae. PLFA analysis provides a fingerprint of the soil food web.
Specific species
Plating methods and DNA techniques are more suitable for identifying specific species.

What are the target values based on?

What are the target values based on?
The target values indicate how the sample scores compare with similar soils or matrices and are based on percentiles of samples taken in practice.
Outdoor and greenhouse soil
The target values of outdoor and greenhouse soil samples are furthermore corrected based on their organic matter content.
Low organic matter
The target values of soils that are poor in organic matter are lower and lie closer together than soils that are rich in organic matter.

When is the best time to take sample for Soil Life Monitor?

Sample taking
The best time to take a sample for Soil Life Monitor depends on the purpose of the analysis.
Over time monitoring
For plots being monitored over time, the best time to take samples is at roughly the same time every year and under similar conditions each time
Activity
Soil life is generally more active in the growing season under warm, moist conditions. In winter, soil life activity slows down and very dry conditions can kill off or largely inactivate soil life.

How does the NIR analysis work?

Near-infrared spectroscopy (NIRS)
Eurofins Agro measures PLFAs using near-infrared spectroscopy (NIRS): a quick, innovative, and reliable method.
NIRS analysis uses PLFA GC-MS as the wet chemistry reference method.
By analysing many samples – both with wet chemistry and with NIRS – the NIRS analysis is calibrated to optimally measure PLFAs in soil samples.

Other FAQ

Equi Feed

Soil Life Monitor

Soil Carbon Check

Pricing & invoices

Documents

Analysis & reports

Taking a sample
